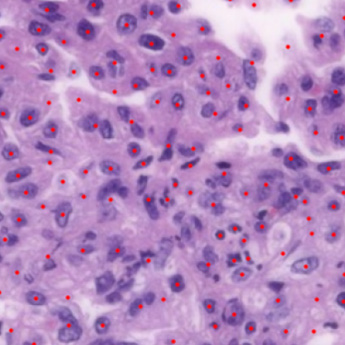

Code on display: A new exhibit at UNESCO

Update: You can catch the show until March 26, 2026 at the Cité des sciences et de l’industrie in Paris. Free entry.
Our world runs on billions of lines of code, but we rarely see it in the wild. It lives behind glass, buried in chipsets, or scrolling past in a terminal. In 2026, for its 10th anniversary, Software Heritage, in partnership with Inria, is pulling the curtain back.
We’re bringing code into the physical world with a Source Code Exhibition, hosted at UNESCO Headquarters in Paris during the 2026 Software Heritage Symposium.
Moving beyond the standard tech showcase, this exhibit repositions source code as the central artifact rather than the background of a digital product. Beyond the logic and the loops, source code is a medium of human expression. It carries the fingerprints of its authors, the social friction of its era, and the aesthetic soul of its creators. It’s a mirror, a testimony, and a cultural relic.
The exhibit tracks the evolution of code from technical utility to cultural weapon. The RSA T-shirt on show by Joel Furr is a relic of the 90s “Crypto Wars.” By printing encryption source code on cotton, cypherpunks bypassed U.S. munitions laws that classified strong math as a weapon. This stunt turned a garment into a “dangerous” export, establishing the legal precedent that code is protected speech.
While RSA used code as a political shield, the Wenyan programming language uses it as a cultural statement. This “relic” edition manual presents a modern functional language written in Classical Chinese, where code is read top-to-bottom and right-to-left. It breaks the global English-dominated syntax, proving that the future of programming can be as diverse as our historical languages.
You’ll also find ELIZA, the 1966 proto-chatbot that proved humans are hardwired to project emotion onto machines; even with a few lines of script mimicking a Rogerian psychotherapist, it famously tricked users into believing the code was “listening.” This nerdy lineage ties directly into the lakeri collective’s Invisible Walls, which hijacks UDP/OSC networking protocols to turn abstract UN statistics into a sensory “sonic mist,” proving that code is as much about performance and activism as it is about data.
The curation
After an international call for entries last June, our committee narrowed down a flood of proposals to 15 core exhibits anchored by three distinct perspectives:
- Source Code as Historical Testimony: Recovering and interpreting the digital record
- Source Code as a Mirror of Society: The politics and power dynamics of the script
- Source Code as Cultural Artifact: Code as pure creative expression

Distributed by design: Explore the exhibit globally
The IRL exhibition kicks off on January 28 at UNESCO in conjunction with the Software Heritage Symposium. If you can’t make it to Paris, keep in mind the exhibit is designed to scale. This is just the start—the collection will morph into a traveling showcase to bring these stories to a global audience.
Catch the exhibition’s first stop at the Cité des Sciences et de l’Industrie’s Fablab in March 2026—free and open to all.
Get involved
You can check out the exhibit online sourcecode-exhibition.softwareheritage.org
Fork the discussion
There’s also a dedicated discussion thread at the Critical Code Studies Working Group. Whether you’re a scholar, a dev, or a digital activist, join the conversation on the ethics and art of code curation.
The discussion is open to all—just register here to get access.
Featured image: Daniel Temkin, Snippet of Rivulet code, 2025 [CC BY 4.0].